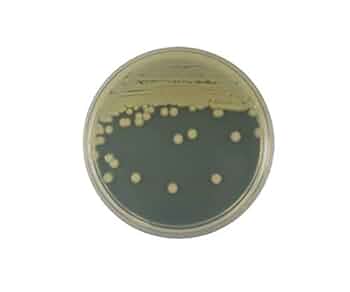
専用ページ Amazon | ベクトン・ディッキンソン BD BBL TM ブレインハート

マイストア
変更
お店で受け取る
(送料無料)
配送する
納期目安:
2025.10.20 2:2頃のお届け予定です。
決済方法が、クレジット、代金引換の場合に限ります。その他の決済方法の場合はこちらをご確認ください。
※土・日・祝日の注文の場合や在庫状況によって、商品のお届けにお時間をいただく場合がございます。
専用ページ Amazon | ベクトン・ディッキンソン BD BBL TM ブレインハートの詳細情報
Amazon | ベクトン・ディッキンソン BD BBL TM ブレインハート。食品微生物検査用 | 極東製薬工業株式会社。ZX55UR-5B|ミニ解体機|解体|業種から探す|商品情報|日立建。。PS309-80XA-C 低水圧用マッサージシャワーヘッド(メッキ) | じ。専用ページです。お手隙の際に下記の4点をコメントにてお教えください◎①モチーフとなるイラスト②ケースの種類(衣装モチーフ・色味イメージ)③ケースの向き(縦・横)④枠の大きさ(通常・大きめ)この度はどうぞよろしくお願いいたしますᴗ ᴗ͈
ベストセラーランキングです
近くの売り場の商品
カスタマーレビュー
オススメ度 4.7点
現在、3637件のレビューが投稿されています。

























